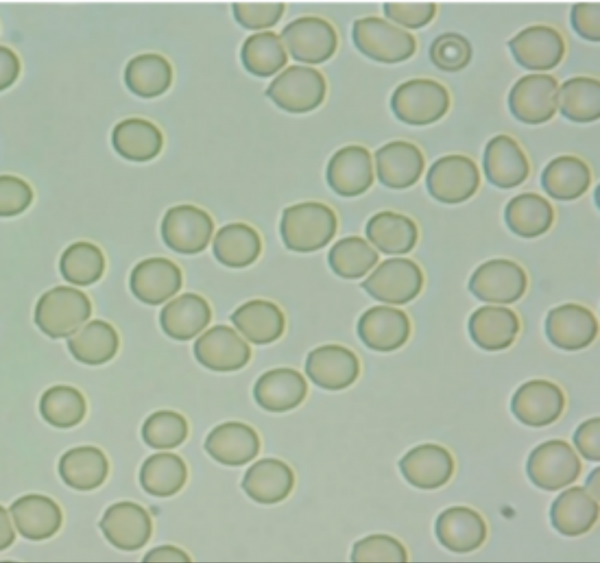
7

惠斯安普
2020年12月2日
PMR微循环治疗系统
正式取得
中华人民共和国医疗器械注册证

惠斯安普
PMR微循环治疗系统在经过
型式检验、项目立项、伦理审查、临床试验、药监局审批等严格的审查流程后
最终取得中华人民共和国医疗器械注册证

标志着PMR微循环治疗系统
获得了医疗市场销售准入资格
该产品在功能疗效,质量标准上,
符合了国家规范标准
其安全性和有效性
满足了临床使用要求
将更好的为全民大健康时代服务
功能医学干预康复设备
PMR通过河北省医科大学第一医院、
河北省中医院、秦皇岛中医院临床试验,
对44种慢病匹配针对性的治疗方案。
临床显示,
尤其对睡眠障碍、疼痛、高血压、
高血脂、高血糖、红细胞聚集、
疲劳恢复等有明显的治疗效果。
临床对比

治疗前
红细胞滚动和变形功能差,红细胞聚集状态+++

第一次治疗后
红细胞滚动和变形功能一般,红细胞聚集状态++

第二次治疗后
红细胞滚动和变形功能一般,红细胞聚集状态+

第三次治疗后
红细胞滚动和变形功能好,红细胞聚集状态-

正常红细胞
严重聚集的红细胞
PMR技术原理
应用仿生脉冲磁共振原理,
结合极低频电磁导入技术及空间电磁场控制技术,
使细胞膜在原有电位基础上,
产生新的跨膜电位,改变膜表面电荷分布,
纠正血流变指标,改善血管舒张功能,
促进血液循环,使病变组织微循环得到良好修复。
仿生脉冲磁共振靶向治疗,定位准确;
无痛安全,无副作用;
修复完成后不易复发。
视频
PMR功能特点
安全:磁场频率控制在3-30Hz,强度小于40μT;
无创:非介入治疗,不对皮肤及器官构成任何伤害;
智能:全智能管理,治疗方案根据疾病类型和患者体质状况自动组合;
无辐射:电磁辐射量相当于手机的十万分之一;
显效快:一般1~2疗程即有明显的效果。

秦皇岛市惠斯安普医学系统股份有限公司成立于2011年,公司占地50亩,是一家专注于生物医学领域医疗设备及系统的设计、开发、生产及销售为一体的高新技术企业。公司拥有生物医学领域的博士、硕士专业研发人才50余名;与国内外多家生物医学研究机构、高等院校和三甲医院建立了长期稳定的合作关系,并设有电磁干扰与静电防护院士工作站、生物医学研究中心和生物医学体验中心。

公司定位:
专注于疾病早期筛查与慢病干预康复领域大型功能医学设备的研发、生产、销售服务。
公司文化:
让生活更美好·让生命更健康
公司愿景:
制造全生命周期健康管理设备,服务生命健康事业更多详细信息请进入秦皇岛市惠斯安普医学系统股份有限公司》》



 找产品
找产品
 招代理商
招代理商 找工作
找工作 查数据
查数据





